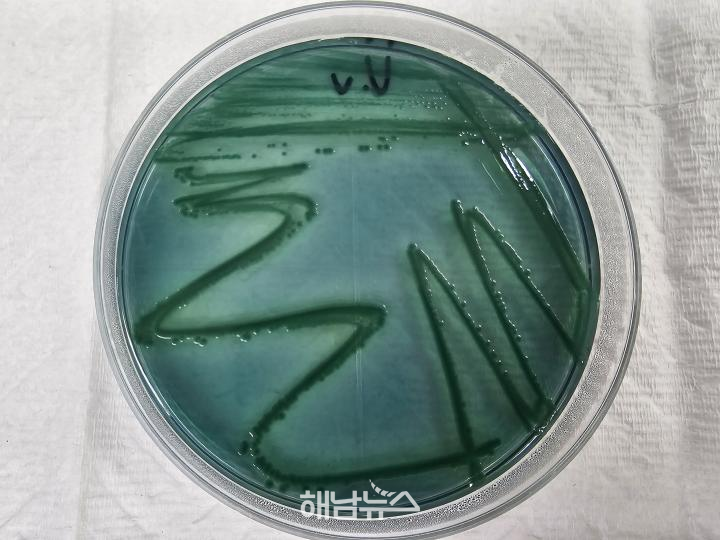

비브리오패혈증균 / 사진제공=전라남도 |
전남 해역에서 치명적 감염병의 시작을 알리는 신호가 포착됐다.
올해 첫 비브리오패혈증균이 검출되면서 지역사회에 긴장감이 높아지고 있다.
전라남도보건환경연구원은 지난 9일 영광 갯벌 해수에서 비브리오패혈증 원인균인 비브리오 불니피쿠스(Vibrio vulnificus)를 확인했다고 밝혔다.
이번 검출은 최근 해수 온도 상승 영향으로 예년보다 빠른 시기에 나타난 것으로, 감염 위험이 조기에 확산될 가능성이 크다는 점에서 우려를 낳고 있다.
그동안 전남도는 질병관리청 호남권질병대응센터와 함께 서·남해안 일대를 중심으로 병원성 비브리오균을 지속적으로 모니터링해 왔다.
그러나 기후변화로 해수 온도가 점차 상승하면서 병원성 균의 활동 시기가 앞당겨지고 기간도 길어지는 경향이 뚜렷해지자, 감시체계를 계절 중심에서 연중 상시 운영 체계로 확대했다.
비브리오패혈증은 단순한 식중독과는 차원이 다른 중증 감염병이다. 오염된 어패류를 날로 섭취하거나 상처 난 피부가 바닷물에 접촉할 경우 감염될 수 있으며, 발열과 오한, 복통 등 증상이 나타난 뒤 24시간 이내 피부 괴사성 병변으로 빠르게 진행되는 것이 특징이다.
특히 치사율이 약 50%에 달해 조기 진단과 신속한 치료가 무엇보다 중요하다.
실제 전남에서는 최근 5년간 38명의 환자가 발생했으며, 이 중 50세 이상이 80% 이상을 차지한 것으로 나타났다.
간 질환자나 당뇨병 환자 등 면역력이 저하된 기저질환자의 경우 감염 시 위험성이 더욱 높아 각별한 주의가 요구된다.
전남도보건환경연구원은 도민들에게 기본적인 예방수칙 준수를 거듭 당부하고 있다.
어패류는 반드시 85℃ 이상에서 충분히 익혀 섭취해야 하며, 피부에 상처가 있는 경우 바닷물과의 접촉을 피해야 한다.
또한 해산물을 다룬 후에는 손과 조리도구를 철저히 세척하는 등 위생 관리가 필요하다.
안양준 전남도보건환경연구원장은 “지구온난화로 해역이 아열대화되면서 병원성 비브리오균 활동이 점차 활발해지고 있다.”며 “감염 예방을 위해서는 무엇보다 일상 속 작은 실천이 중요하다.”고 강조했다.
이번 첫 검출은 단순한 계절적 현상이 아니라 기후변화가 만들어낸 새로운 감염병 환경의 시작이라는 점에서 의미가 크다.
바다를 삶의 터전으로 삼고 있는 전남 지역일수록 생활 속 예방수칙을 철저히 지키는 것이 곧 건강과 생명을 지키는 가장 현실적인 대응책이 되고 있다.
 비브리오패혈증균 검사 / 사진제공=전라남도 |
“A Deadly Bacterium in the Sea Has Already Emerged”
First Detection of Vibrio vulnificus in Jeonnam This Year… 50% Fatality Rate, Urgent Need for Early Response
【Jeonnam = Haenam News】haenamnews@kakao.com
A warning signal of a deadly infectious disease has been detected in the coastal waters of Jeonnam. With the first confirmed presence of Vibrio vulnificus this year, concerns are rising across the local community.
According to the Jeollanam-do Institute of Health and Environment, the bacterium responsible for Vibrio septicemia (Vibrio vulnificus) was identified on the 9th in seawater from the mudflats of Yeonggwang. This early detection, occurring sooner than usual due to rising sea temperatures, has heightened concerns about a faster spread of infection risk.
Jeonnam Province has been continuously monitoring pathogenic Vibrio bacteria in cooperation with the Korea Disease Control and Prevention Agency’s Honam Regional Center, focusing on the west and south coasts. However, as climate change accelerates sea temperature increases, the activity period of these bacteria has started earlier and lasted longer. In response, the monitoring system has been expanded from a seasonal operation to a year-round surveillance system.
Vibrio septicemia is not a simple foodborne illness but a severe and potentially fatal infectious disease. Infection can occur through the consumption of raw or undercooked seafood contaminated with the bacteria, or when open wounds come into contact with seawater. Symptoms include fever, chills, and abdominal pain, followed by rapidly progressing necrotic skin lesions within 24 hours.
The fatality rate is approximately 50%, making early diagnosis and prompt treatment critically important. Over the past five years, 38 cases have been reported in Jeonnam, with more than 80% of patients aged 50 or older. Individuals with underlying conditions such as liver disease or diabetes, or those with weakened immune systems, face significantly higher risks and must take extra precautions.
The Institute is strongly urging residents to follow basic preventive measures. Seafood should be thoroughly cooked at temperatures above 85°C, and individuals with open wounds should avoid contact with seawater. Proper hygiene, including thorough handwashing and cleaning of utensils after handling seafood, is also essential.
Ahn Yang-jun, Director of the Jeonnam Institute of Health and Environment, emphasized, “As global warming leads to the subtropicalization of our coastal waters, the activity of pathogenic Vibrio bacteria is becoming increasingly active. Prevention ultimately depends on small but consistent daily practices.”
This first detection is not merely a seasonal occurrence but a sign of a new infectious disease environment shaped by climate change. For regions like Jeonnam, where daily life is closely tied to the sea, strict adherence to preventive measures is now the most practical and essential way to protect health and lives.
 해남뉴스 박충배 편집 및 논설위원 haenamnews@kakao.com
해남뉴스 박충배 편집 및 논설위원 haenamnews@kakao.com 2026.05.03 (일) 21:22
2026.05.03 (일) 21:22


































